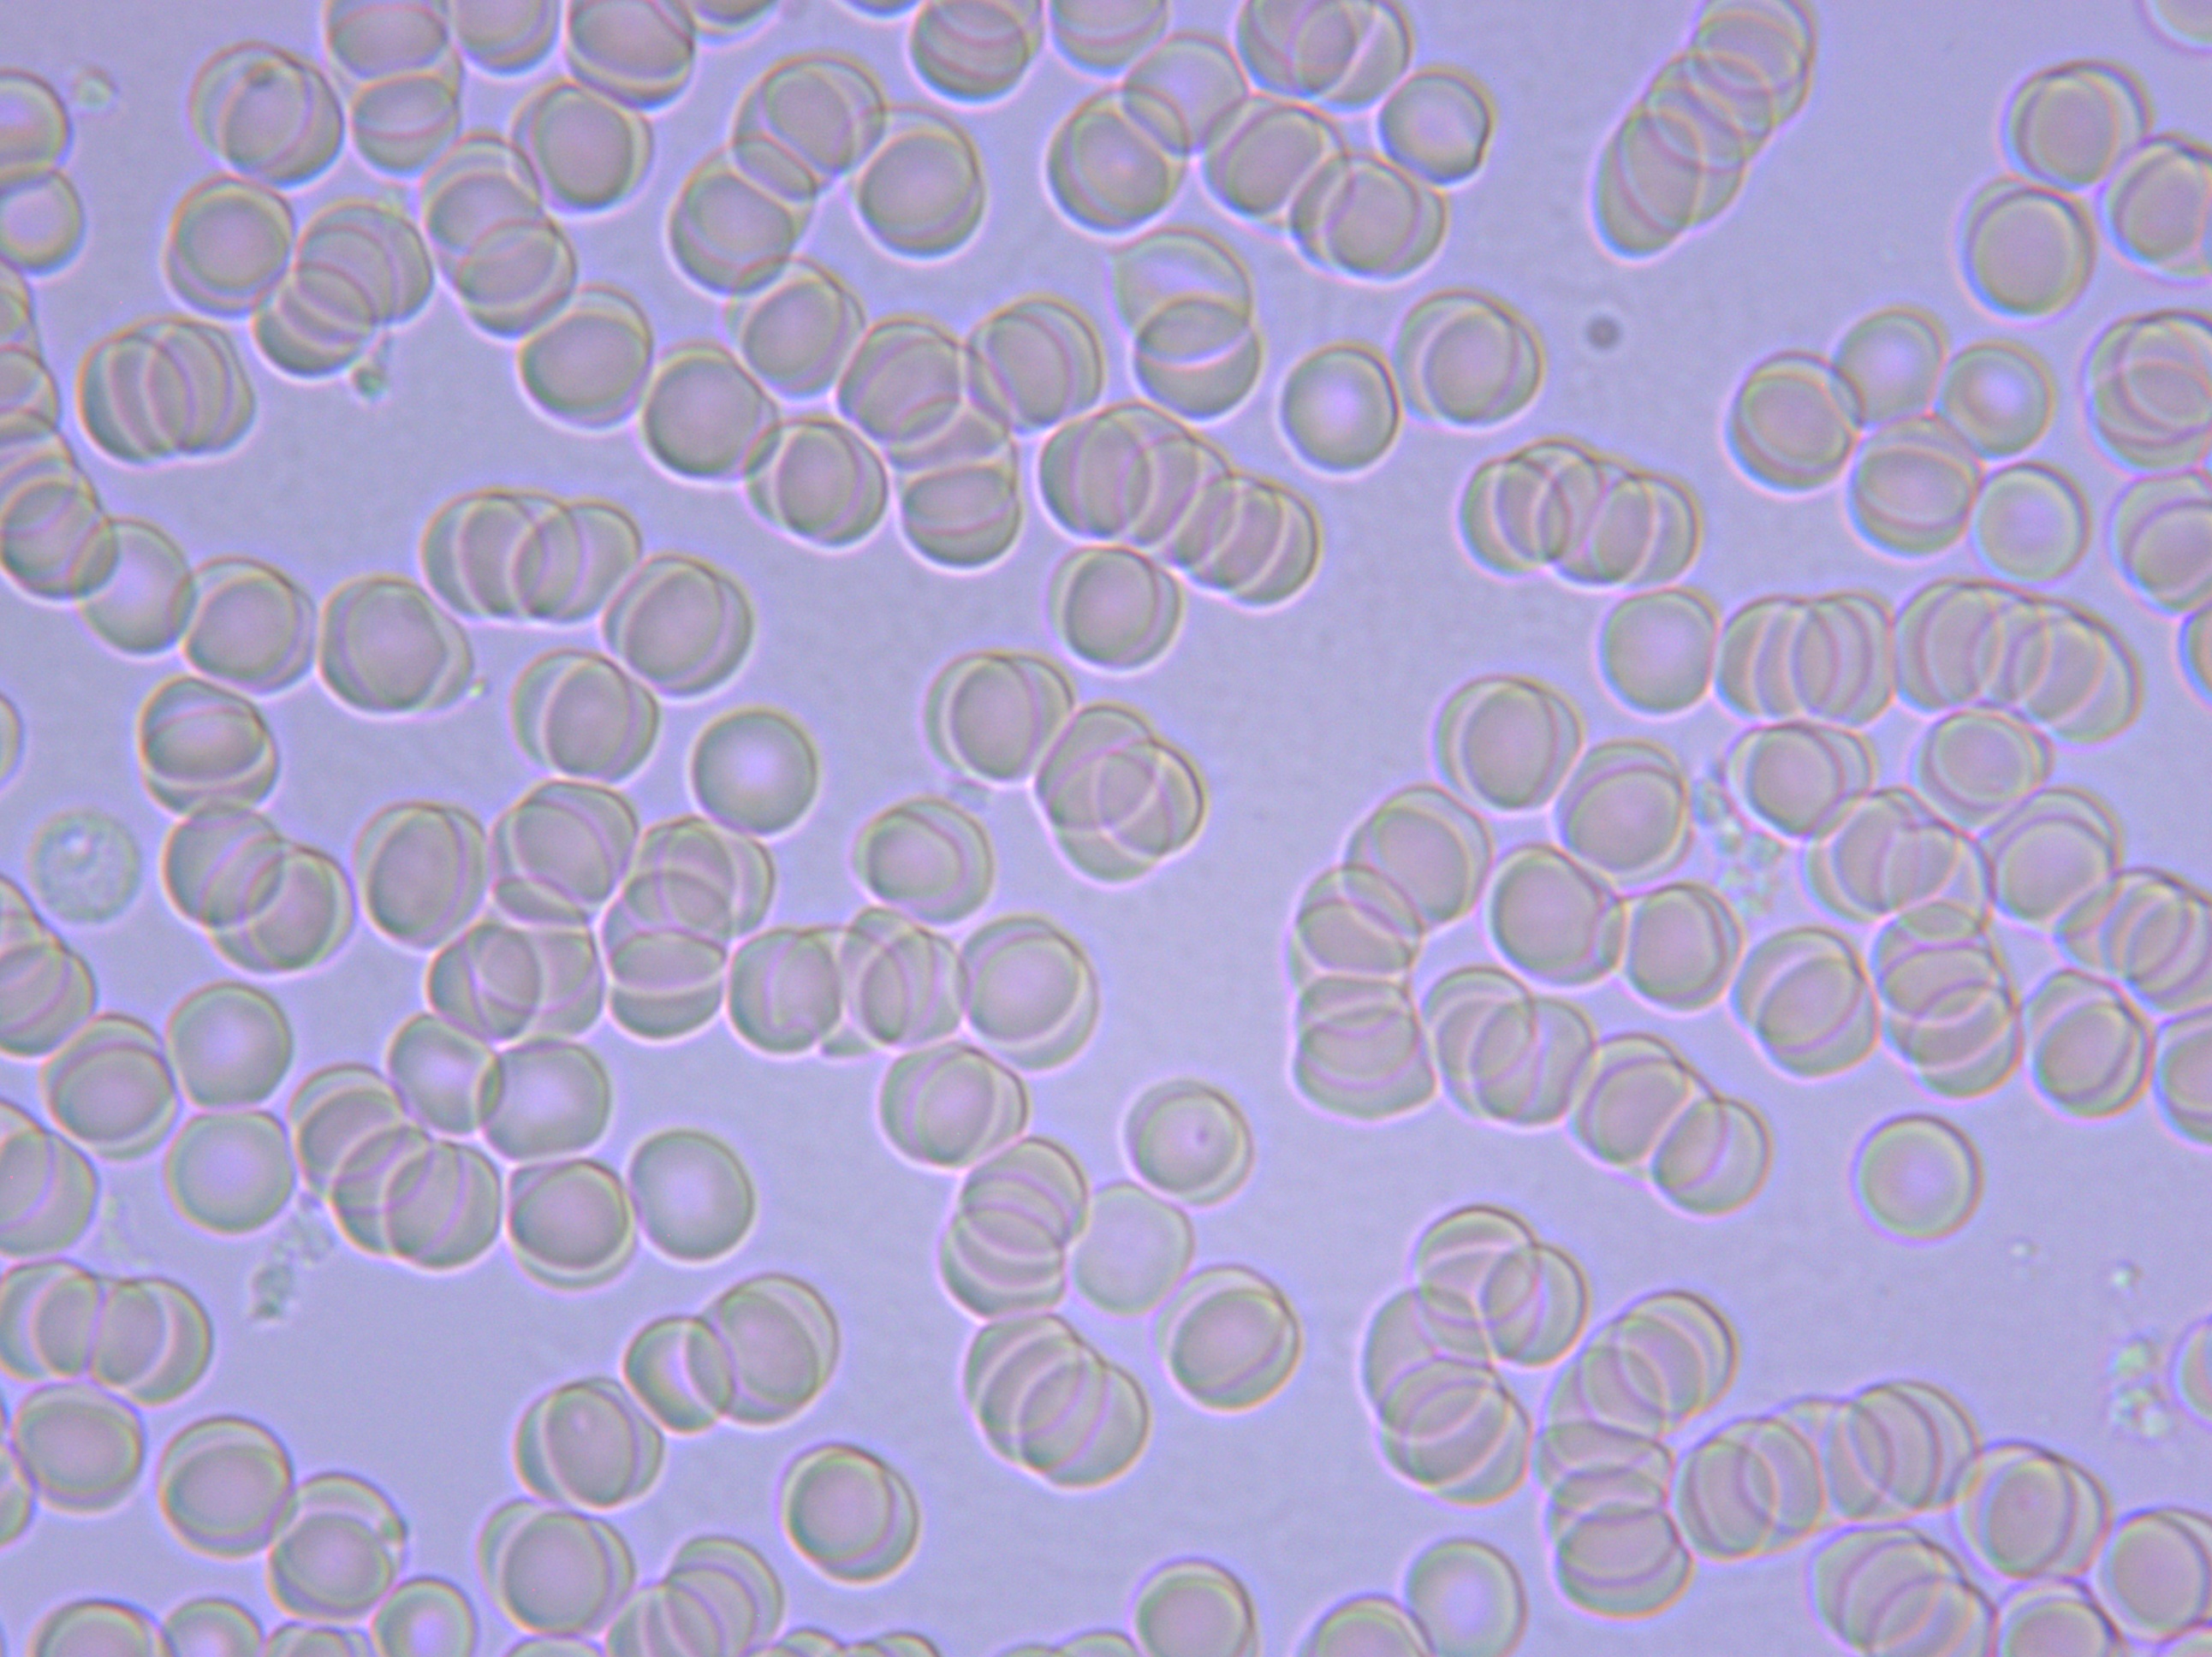
血液粘稠的病因及治疗,健康血液粘稠别小看但也别乱治

医学界的朋友们:
你们好!
我的发现可能让你们震惊,是用普普通通的显微镜,却发现了医学界忽略的血液粘稠,它会引起若干疾病,当净化后可以康复若干疾病。
如下图所示,我最初的血液图片,以前的血液重度粘稠时多病缠身,到后来净化到近健康状态时若干疾病消失,希望能引起有关专家的重视,着手研究血液粘稠的危害和净化血液后带给病人的好处,以及如何净化血液。

我的发现也是无意间的。(用时两年,并多人)
我以前是一个多病的人,吃药无数、住院无数、依然是旧病不去,新病又添,简单的罗列一下近20年的症状:
从35岁左右开始出现怕冷、腿凉的症状,夏天穿秋裤,午睡盖被子;
近20年的慢性胃炎,有十二指肠球炎;
2011年3月患腔梗,后遗症有时是舌头发木,有时咬舌头,吐字不清,易犯困;
2015至2017年期间免疫力极低,近月月感冒,而且必须输液才会治好。
近十年时间内脸色苍白、嘴唇发紫;
2016年12月检查发现慢性肝损伤。
每天被疾病所困,中药、西药都离不开,身体每况愈下。
从在2017年7月,开始尝试进行调理,也正是有了用显微镜的观察才发现血液的变化能康复若干疾病,六个月血液发生了巨大的变化,由重度粘稠到变稀的状态(健康状态),以前的一些症状不药而愈,从此停掉了所有的药物。
下面是2017年7月调理最初的重度粘稠血液,红细胞成堆粘连,分不清个数,但化验指标在正常范围之内。

两个月后观察:

三个月后观察:

血液有明显变化,红细胞清晰了很多,感觉到以前频繁的口吃,舌头发木症状明显减少,其它的感觉没什么。
至2018年1月4日时,血液变成下面的样子了(六个月了);

当时看了这样的血液吓了一跳,怎么会是这个样子,显微镜下红细胞是分散开的,互相不挨着。询问医生被告之这样的血液才是正常的,血液中的红细胞本来就是分散、游离状的,因为其带有负电荷,互相排斥的结果,排斥是为了更好的携带氧气和营养物质,粘稠是因为血液中的脂类物质粘附在红细胞壁上,形成脂质膜,使负电荷无法释放,红细胞之间失去了排斥力,同时脂类物质具有粘性,因此红细胞相互间开始粘连,出现血液粘稠,并告诉我这是健康的标志。
下面是2018年3月4日和2018年4月13日的血液

下面两张是2108年6月和8月观察的血液。

到2018年8月,观察血液一年,变化如下:
不再怕冷,腿也不凉了,夏天首次把秋裤脱掉,中午睡觉不用盖被子了;
有近半年多时间没有感冒,免疫力增强;
腔梗后遗症也没有了,吐字清晰、不咬舌头了;
在北京*013院医**检查慢性肝损伤也好了。
除有慢性胃炎外,其余的疾病都没有症状了;
现在精力充沛,开车10个小时感觉不到累;
停掉所有的药物半年时间了,省钱又减少药物对身体的伤害。
继续观察至2019年1月12和2019年4月1日的血液

观察至此近2年的时间,血液接近孩子的血液状态,最初的症状都消失了,没有复发,我又重新回到健康状态,这是我想象不到的。
没有对比就没有发现。
正是观察到一个是七岁小女孩的和一个是81岁的老人的血液才发现和证明了血液对人体的健康是如此的重要,下面的照片:

小孩的血液当然是健康的了,因此精力充沛,免疫力高。

在我观察的人中,很多不到40岁时已经是重度粘稠了,(下面的图片),如此怎能与80岁的老人相比,这些人都伴随有一些慢性疾病,如血脂高、脑供血不足、 心脏病、腔梗、高血压、心肌缺血、腰脱、腿疼、手脚凉、尿酸高等。


如此血液怎能有一个健康的身体。
如果仅一个受益者,个例不具有代表性,下面举几个例子:
案例一:
王先生:赤峰市敖汉旗人,血淤体质,视网下静脉栓塞5年历史,后遗症是视物有波浪线,影响开车和看手机,对生活有一定影响。
这是他前后的血液图片对比。

血液变成第二张时,他的血淤体质已经改变,视物中的波浪线形状也由以前的浪波线变成一个小黑点,基本上不影响生活了。
案例二
陈女士:内蒙古赤峰市敖汉旗医院退休的护士,心肌缺血,上楼时心脏有隐隐的疼痛,气短,嘴唇发紫,最初血液属重度粘稠。

使用产品两个月后,血液变成轻度粘稠时,她当初的症状也随之消失。
案例三:
刘武:赤峰市敖汉旗人,他是高血脂5.7、高血压150、血糖10、抽烟,使用产品连续观察了六个月,
血液变化情况见下图:

历时六个月由重度粘稠变为中度,并且出现大量的单个红细胞,此时血脂降为2.4、血压降为130左右、血糖降为6.17。这是我观察所有人中血液粘稠变化最慢的,应该是多种原因吧,如血糖高、抽烟、吃肉、不良饮食习惯等引起的。
案例四:
林老师,敖汉旗一名教师,手关节痛,腰间盘脱出,压近近、迫神经腰痛、环跳、腿痛、心脏刺痛、怕冷、嘴唇发紫。

两个月后以上症状消失,只有手指关节痛。
案例还有腰脱康复的,高血压下降的等等近40人。
很多人在医院化验血液各项指标都是正常的,那是因为是化验血液中的某些项指标的含量,这种化验方法只关注某些物质在血液中的含量,而不是关注这些物质在血液中哪里存在,其实有些脂类物质是没有超标,可是已经粘附在红细胞身上了,这些物质的粘附造成的血液粘稠。因此显微镜观察的是红细胞粘连的情况,生化检查的是含量,生化指标正常不代表血液不粘稠,不要被正常指标蒙蔽,血液粘稠会引起一系列疾病。
显微镜观察只要两个红细胞相连,就足以说明这两个红细胞身上一定包裹脂类物质,这个现象直观的说明脂类垃圾在红细胞身上粘附着,血液粘稠对人体的危害分析:
- 红细胞负责运输氧气和营养物质,红细胞粘连,携氧量下降,自然引起心脑供血不足现象;
- 粘稠的血液束缚了代谢物在排泄器官中的排泄,从而使排泄效率降低,使血液中的垃圾增加,影响身体的健康;
- 粘稠的血液中一定裹携着一些代谢物,使其在体内积存时间变长,在破坏了体质环境,使PH值发生微小的变化,会影响新陈代谢的正常进行,从而引起内分泌紊乱,形成代谢类疾病,如肥胖、营养不良、糖尿病等;
- 粘稠血液的粘附力也会束缚免疫物质如抗体和白红胞灭杀病菌的效率,造成病菌入侵肌体成功,引起炎症类疾病;
- 粘稠的血液中毛细血管中流动,脂类物质也会粘附在毛细血管壁上,造成毛细血管管壁网眼被堵塞,直接影响氧气和营养的通过,影响细胞的健康,同时代谢物进入毛细血管也受阻,形成微循环障碍,微循环障碍引得百病生,危害更大。但是脂类物质粘附在红细胞壁和毛细血管壁上不是病变,红细胞依然是红细胞,毛细血管依然是毛细血管,只是物理粘附,医学界应该着手研究如何将脂类物质清理下来,并排出体外,从而达到净化血液、清理毛细血管,改善微循环,清理淤堵的效果 。
如果一个人一生的血液中的红细胞分散、游离状,互相不粘连,血液中的垃圾也少,这个人一生一定是健康的。
中医常讲“血淤”,那“血淤”说的血是什么样子的?
用显微镜观察过血液的状态吗?是粘稠还是稀释的?不得而知,有了显微镜的观察做为证据。
中药调理有“活血化淤”功效,字面理解应该是降低血液粘稠度,清理淤堵,经过中药调理,那最终的结果又是怎么个样子呢?生化检测根本观察不到,只有用显微镜才观察到。有的物理方式能净化血液、输通毛细血管,改善微循环,从而达到与中药调理“活血化淤”的功效,殊途同归。
说到这里可以得出一个结论:
血液粘稠会生病,而净化血液可以康复一些疾病。
(在净化的过程中,血液净化与毛细血管净化是同步进行的,使血液净、毛细血管畅通,微循环得以改善,消除某些慢性疾病是肯定的。)
我的发现希望引起医学界人士的高度关注,进行科学的调研、分析、论证,是否能证明血液粘稠会引起疾病,通过净化恢复到健康状态,对某些疾病有康复效果,不论使用什么产品,只要达到净化血液的效果就可以,有没有效果用显微镜就可以观察,直观的就可以看见红细胞是分散的,还是粘连的,一目了然,无法做假。
(发此微信的目的是引起研家的重视,只提供发现的素材,不提供所使用的产品信息,待专家、学者论证后再告之,一定会有更多的设备或药品或保健品上市,并制定显微镜检测血液的标准和检测方法,并推广之普及,让百姓受益。)
素材提供人:张先生
有意调研者加微信沟通(恕不留电话)

张先生
2019年8月25日星期五